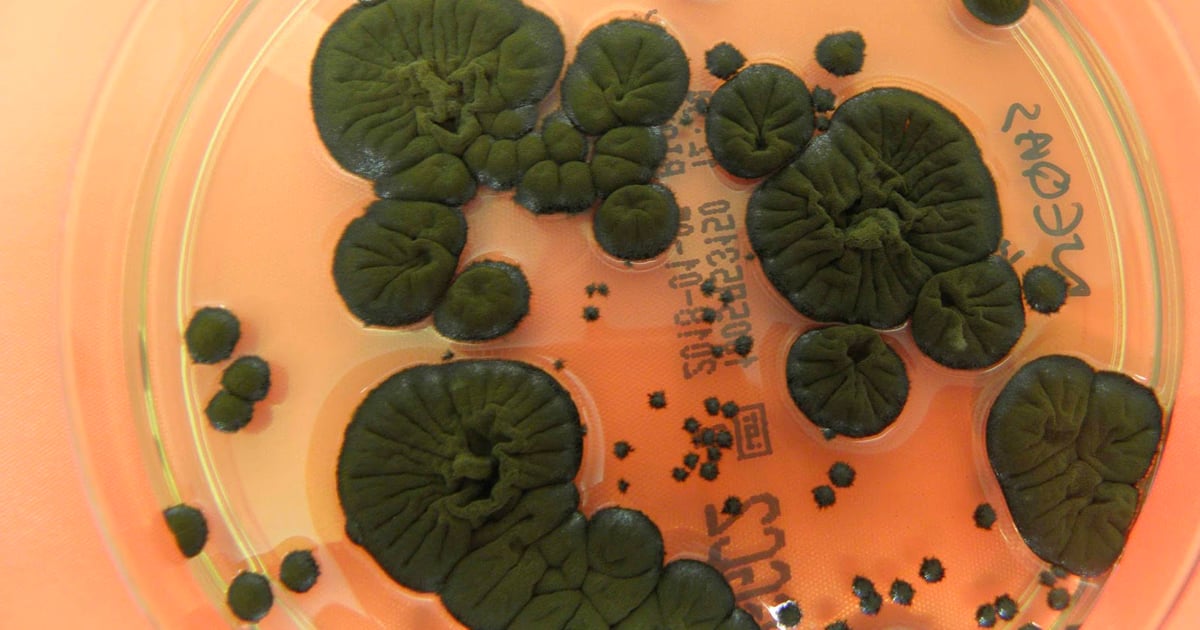
Featured image for Radiation-Absorbing Fungus Converts Nuclear Fallout into Energy

Brontë’s edge, neutered: Vox critiques Fennell’s Wuthering Heights
Vox’s Constance Grady argues Emerald Fennell’s Wuthering Heights fetishizes style over Brontë’s brutal tension, neuters Heathcliff and Catherine, and shifts Nelly Dean into a villain, resulting in a film that provokes little and mirrors more of a Nicholas Sparks vibe than Brontë’s edge.